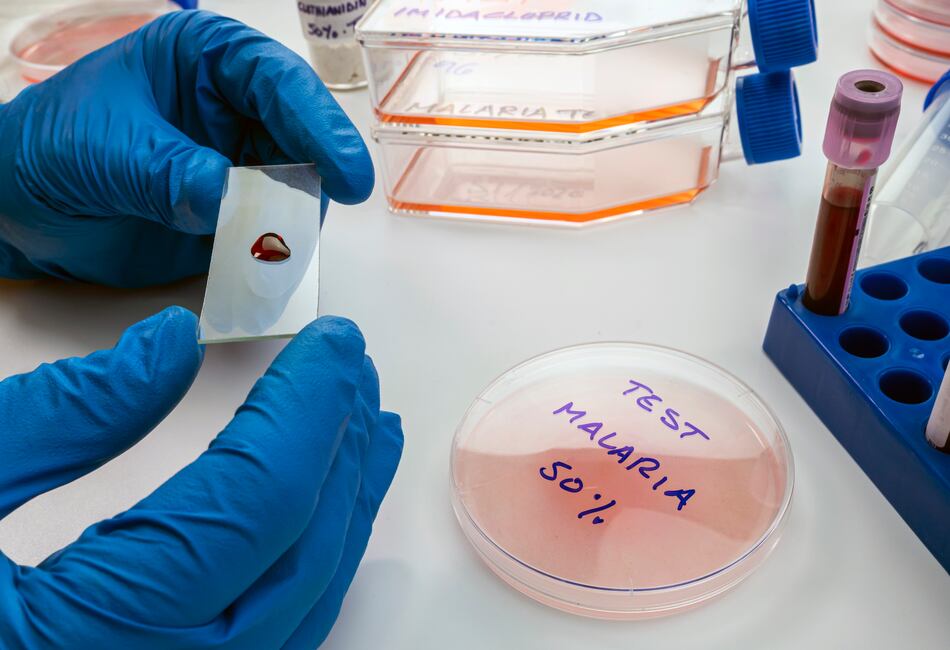
Panamá tiene 2 mil 661 casos acumulados de malaria en  los primeros tres meses  del 2023

Los casos de malaria en Panamá no dan tregua a las autoridades del Ministerio de Salud (Minsa).
El último informe del Departamento de Epidemiología del Minsa, muestra que hasta la última semana de marzo pasado había 2 mil 661 casos acumulados de malaria en el país.
Las áreas con mayor cantidad de casos son la comarca Guna Yala (995 casos), le sigue Darién (865), la comarca Ngäbe Buglé (452) casos y Panamá este (182).
De hecho, en enero pasado el Minsa instaló un centro de operaciones contra la malaria para coordinar de manera institucional las estrategias que se llevarán a cabo para hacer frente a la enfermedad transmitida por el mosquito hembra Anopheles.
Además, las autoridades aseguran que han reforzado las estrategias de promoción y prevención de la malaria en las áreas con mayor cantidad de casos, distribuyendo mosquiteros con químicos e igualmente, reforzando la capacidad operativa y el abastecimiento de medicamentos contra esta enfermedad en todo el país.
El aumento de casos obedece a la disminución en el cumplimiento de los programas, reconoció el Departamento de Control de Vectores del Minsa, ya que debido a la crisis sanitaria no se pudo reclutar a tiempo personal, ni adquirir los insumos, debido a que el presupuesto durante un tiempo determinado se destinó a la contingencia por la covid-19.
El año 2022 cerró con 7 mil 112 casos de malaria, según datos del Minsa.